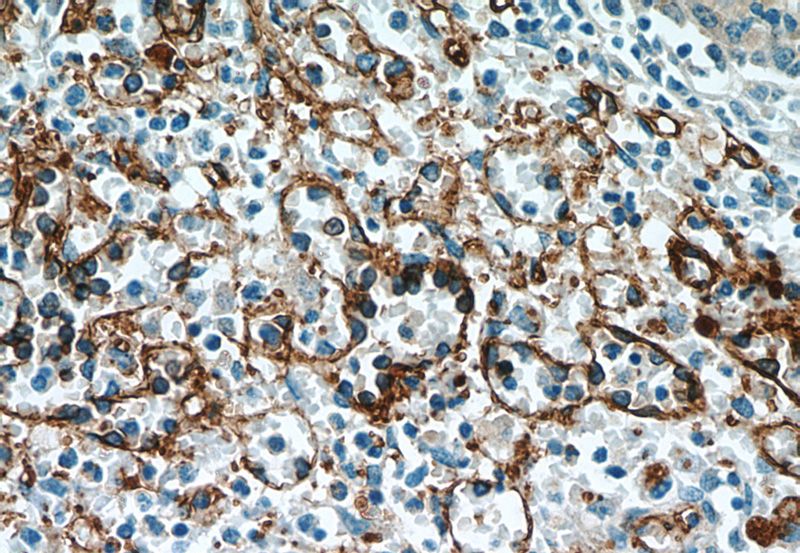
Immunohistochemical of paraffin-embedded human spleen using Catalog No:109031(CD36 antibody) at dilution of 1:50 (under 40x lens)

-
Product Name
CD36 antibody
- Documents
-
Description
CD36 Rabbit Polyclonal antibody. Positive IHC detected in human spleen tissue, human heart tissue. Positive FC detected in RAW 264.7 cells. Positive WB detected in RAW 264.7 cells, HeLa cells, HepG2 cells, HL-60 cells, mouse liver tissue, mouse spleen tissue, RAW264.7 cells. Observed molecular weight by Western-blot: 88 kDa
-
Tested applications
ELISA, WB, FC, IHC
-
Species reactivity
Human, Mouse; other species not tested.
-
Alternative names
CD36 antibody; CHDS7 antibody; FAT antibody; Fatty acid translOCase antibody; Glycoprotein IIIb antibody; GP3B antibody; GP4 antibody; GPIIIB antibody; GPIV antibody; PAS 4 antibody; PAS IV antibody; PASIV antibody; Platelet collagen receptor antibody; Platelet glycoprotein 4 antibody; Platelet glycoprotein IV antibody; SCARB3 antibody; Thrombospondin receptor antibody
-
Isotype
Rabbit IgG
-
Preparation
This antibody was obtained by immunization of Peptide (Accession Number: XM_047421047). Purification method: Antigen affinity purified.
-
Clonality
Polyclonal
-
Formulation
PBS with 0.02% sodium azide and 50% glycerol pH 7.3.
-
Storage instructions
Store at -20℃. DO NOT ALIQUOT
-
Applications
Recommended Dilution:
WB: 1:200-1:2000
IHC: 1:20-1:200
-
Validations

RAW264.7 cells were subjected to SDS PAGE followed by western blot with Catalog No:109031(CD36 antibody) at dilution of 1:500

Immunohistochemical of paraffin-embedded human spleen using Catalog No:109031(CD36 antibody) at dilution of 1:50 (under 10x lens)
Immunohistochemical of paraffin-embedded human spleen using Catalog No:109031(CD36 antibody) at dilution of 1:50 (under 40x lens)

1X10^6 RAW 264.7 cells were stained with 0.2ug CD36 antibody (Catalog No:109031, red) and control antibody (blue). Fixed with 90% MeOH blocked with 3% BSA (30 min). Alexa Fluor 488-congugated AffiniPure Goat Anti-Rabbit IgG(H+L) with dilution 1:1000.
-
Background
CD36, also named as GP3B and GP4, seems to have numerous potential physiological functions. CD36 binds to collagen, thrombospondin, anionic phospholipids, long chain fatty acids and may function in the transport and/or as a regulator of fatty acid transport and oxidized LDL. CD36 may function as a cell adhesion molecule. It mediates cytoadherence of Plasmodium falciparum parasitized erythrocytes. Mutation of CD36 will cause platelet glycoprotein IV deficiency which known as CD36 deficiency. Genetic variations in CD36 are associated with susceptibility to coronary heart disease type 7 (CHDS7). This antibody 18836-1-AP is raised against a synthesized peptide of 100-116 amino acids of CD36.
-
References
- Wu B, Ueno M, Kusaka T. CD36 expression in the brains of SAMP8. Archives of gerontology and geriatrics. 56(1):75-9. 2012.
- Hu YW, Ma X, Huang JL. Dihydrocapsaicin Attenuates Plaque Formation through a PPARγ/LXRα Pathway in apoE(-/-) Mice Fed a High-Fat/High-Cholesterol Diet. PloS one. 8(6):e66876. 2013.
- Hu YW, Yang JY, Ma X. A lincRNA-DYNLRB2-2/GPR119/GLP-1R/ABCA1-dependent signal transduction pathway is essential for the regulation of cholesterol homeostasis. Journal of lipid research. 55(4):681-97. 2014.
- Singh AK, Joharapurkar AA, Khan MP. Orally active osteoanabolic agent GTDF binds to adiponectin receptors, with a preference for AdipoR1, induces adiponectin-associated signaling, and improves metabolic health in a rodent model of diabetes. Diabetes. 63(10):3530-44. 2014.
- Hu YW, Zhao JY, Li SF. RP5-833A20.1/miR-382-5p/NFIA-dependent signal transduction pathway contributes to the regulation of cholesterol homeostasis and inflammatory reaction. Arteriosclerosis, thrombosis, and vascular biology. 35(1):87-101. 2015.
- Matsumoto K, Chiba Y, Fujihara R, Kubo H, Sakamoto H, Ueno M. Immunohistochemical analysis of transporters related to clearance of amyloid-β peptides through blood-cerebrospinal fluid barrier in human brain. Histochemistry and cell biology. 144(6):597-611. 2015.
- Zhao YP, Li L, Ma JP, Chen G, Bai JH. LXRalpha gene downregulation by lentiviral-based RNA interference enhances liver function after fatty liver transplantation in rats. Hepatobiliary & pancreatic diseases international : HBPD INT. 14(4):386-93. 2015.
- Liu M, Zhang W, Li X, Han J, Chen Y, Duan Y. Impact of age and sex on the development of atherosclerosis and expression of the related genes in apoE deficient mice. Biochemical and biophysical research communications. 469(3):456-62. 2016.
Related Products / Services
Please note: All products are "FOR RESEARCH USE ONLY AND ARE NOT INTENDED FOR DIAGNOSTIC OR THERAPEUTIC USE"
